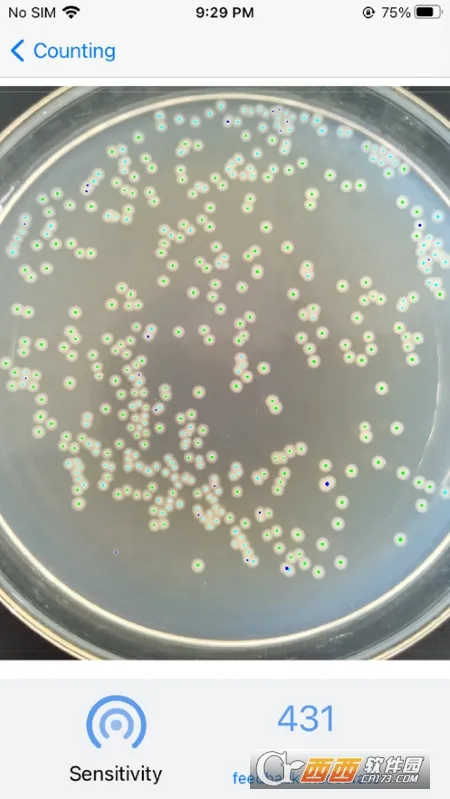

分类

精点相机是一款结合人工智能与移动App的拍照软件,能对图片进行智能分析计数。它优势众多,如对背景、杂物干扰、物体尺寸无要求,支持多分类统计等,还提供丰富模板库及多种功能,适用于多领域。
精点相机是一款超实用的计数拍照软件。它能通过拍摄物品进行计数,不管是钢管、菌落还是黑豆等,都能提供便捷计数体验。有数百种物品点数模板,还支持定制。它功能强大,多分类统计能一次性统计多种分类物品并计算数量;对物体尺寸无要求,各种尺寸物品都能准确统计;多分类细微差别统计可区分相似物品,如药品是否残次。而且对图片背景无要求,复杂图片中也能轻松识别目标物体,杂物干扰过滤效果强。它还有历史记录保存功能,结果既能本地存储,也能云端存储。关于大家关心的是否免费,文中虽未提及,但它功能这么强大,即使收费相信也物超所值,能满足多种计数场景需求,强烈推荐试试!

1. 支持云同步,能跨设备访问数据,不过不同版本存在差异。
2. 模板库场景多样,涵盖农林、建筑、生物医药等,用户可按需选择。
3. 历史记录可本地或云端存储,方便后续随时查看统计结果。

1. 提供不断更新的模板库,用户可通过模板库选择符合自己要求的模板进行统计。
2. 提供拍照和从相册选择两种识别方式,还具备区域圈选功能,更准确快速地进行识别。
3. 拥有历史记录功能,可以将结果进行保存以便之后查看,并且支持多种物品同时统计。
4. 具有人工纠正功能,当对生成的结果存在疑问或觉得不够精准时,能够轻松进行人工纠正操作,确保最终结果符合期望。

1、分类清晰,找应用不费劲,体验超棒。
2、资源超全,冷门工具也能轻松搜到。
3、广告极少,不会跳出一堆东西干扰。
4、用着顺手,下载速度也很快。